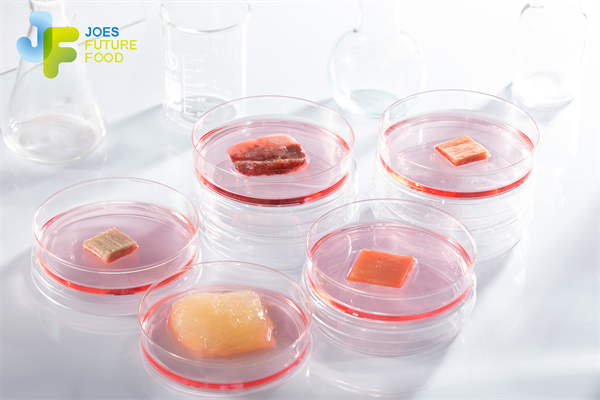
01ba1f6edc7d42249551dcd61508f0c9.png

解码溧水乡村振兴|科技驱动农业产业向“新”提质
近年来,溧水大力发展都市型现代农业,完善城乡融合发展体制机制,持续推进富民增收,在2023年度江苏省推进乡村振兴战略实绩考核中获县(市、涉农区)第一等次首位,至此已连续四年获全省综合第一等次。
编者按:
南京市溧水区是典型的低山丘陵地区,农业资源禀赋突出。近年来,溧水大力发展都市型现代农业,完善城乡融合发展体制机制,持续推进富民增收,在2023年度江苏省推进乡村振兴战略实绩考核中获县(市、涉农区)第一等次首位,至此已连续四年获全省综合第一等次。近期我们将发布系列解读稿件,展现溧水加快发展农业新质生产力,引领乡村振兴的新面貌。
实现农业现代化,必须把强化农业科技支撑摆在突出位置。近年来,溧水推进智慧农业和培育新兴农业产业齐头并进,让农业高质量发展成色更足。
在溧水区白马镇苏辉果蔬专业合作社(以下简称“苏辉果蔬”)的蓝莓种植园内,一块电子显示屏悬挂在大棚中央,依托智慧农业物联网系统,温度、光照、湿度等棚内环境数据在显示屏上清晰可见,工作人员通过手机APP就可以远程启闭遮阳遮雨、加湿、通风等设施,调控棚内环境,使之达到适宜蓝莓生长的条件,节约人工成本的同时还提高了蓝莓的品质。

(苏辉果蔬蓝莓种植大棚)
上世纪80年代后期,白马镇就成为了我国最早开展蓝莓种植的地区之一。“如今,溧水蓝莓已从‘传统靠天’转变为‘科技赋能’,种植技术走在全国前列。”溧水区农业农村局种植业科科长、园艺推广研究员王忠军说。
传统露天种植模式下,蓝莓普遍一亩地产量在800到1000斤,且按照自然生长周期,果实通常在五六月上市,每斤价格在15至20元。苏辉果蔬800亩生产基地在农业物联网技术加持下,不仅一亩地产量能达到3000到4000斤,而且数字栽培系统能缩短蓝莓的生长周期,让蓝莓在春节前上市,此时一斤单价可达到200元。
不单单是以数字化手段调节产量,苏辉果蔬还坚持技术改造,实现品种品质提升。比如,聘请技术团队,引进水肥配方和自动化施肥技术,实现蓝莓品质提升、产量提升、采摘时间提前三方面效益;与南京林业大学、江苏省中科院植物研究所等高校院所的蓝莓专家团队合作,共同进行蓝莓品种培优、组培扩繁、产品开发等。“现在已经形成了‘云南有的品种我们有,云南没有的品种我们也有’的局面。”苏辉果蔬理事长周辉说。
在溧水,像苏辉果蔬这样以数字化、智能化赋能现代农业生产的实例还有很多。南京蜻蜓智慧农业研究院有限公司打造蜻蜓生态循环无人农场,配套农作物耕种管收全环节“无人”农机,让农业生产从人工为主向以机器为主转变;深能南京植物工厂用智能LED灯、新风系统和二氧化碳供给系统模拟生长环境,搭建自动化调节栽培车间环境,实现蔬菜全年供应,而且缩短了蔬菜生长周期,提高了产量……
目前,溧水拥有智能化设施栽培面积4.5万亩、智能化设施畜禽养殖面积16.8万平方米、智能化设施水产养殖面积2.57万亩,全区新型农业经营主体中应用物联网技术的达50家。此外,以全国农业科技现代化先行县建设为契机,溧水已实施蔬菜智能化生产、五莓智慧农业、智慧茶园等农业科技示范项目6个。
在以数字驱动农业高质量发展的同时,溧水也在着力培育新兴农业产业,周子未来食品科技有限公司(以下简称“周子未来”)就是其中的典型代表。
周子未来于2019年落户位于白马镇的南京国家农业高新技术产业示范区,企业率先建立了细胞培养肉全产业链生产研发平台,并在2023年成功实现世界首次细胞培养猪脂肪中试(500L生物反应器)放大生产,打通了猪细胞培养肉全面规模化生产路径,已成为国内领先的细胞培养肉技术研发公司。
(周子未来生产的各种细胞培养肉)
“细胞培养肉作为一种新型蛋白来源,是传统肉类的有益补充,也可以满足消费者多样化的食物与营养需求,并提供了一种更可持续和环境友好的消费选择。既符合我国大食物观战略要求,有利于保障食物与营养安全,也有利于实现农业系统‘碳达峰、碳中和’目标,为食品产业带来转型升级与高质量发展的机遇。”周子未来的工作人员介绍说。
下一阶段,周子未来将对标国外细胞培养肉头部公司,建立“科研—生产—商业”一体化的集成中心。公司计划2024年建设完成更大规模的细胞培养肉中试产业线,提交食品安全性审批,2025年实现产品上市。
目前,南京国家农高区已落户农业科技项目372个,农业高新技术企业16家,市级以上科研平台95个,中国东部(南京)农业科技创新港一期工程已经完工,正朝着现代农业产业创新高地逐步迈进。(肖心月)
编辑:赵鼎
声明:新华财经为新华社承建的国家金融信息平台。任何情况下,本平台所发布的信息均不构成投资建议。如有问题,请联系客服:400-6123115













